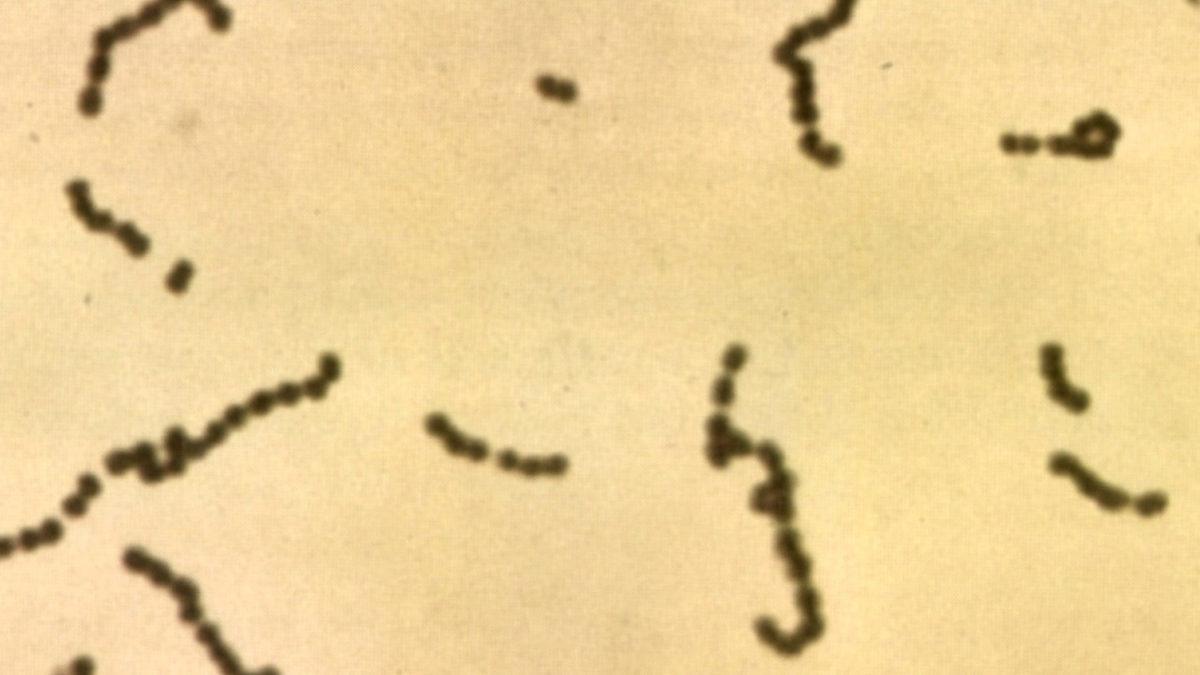
’Strep A’ Bakterisi Yüzünden Çocuğunu Kaybeden Bir Annenin Anlattıkları ve Hastalıkla İlgili Bilmeniz Gerekenler
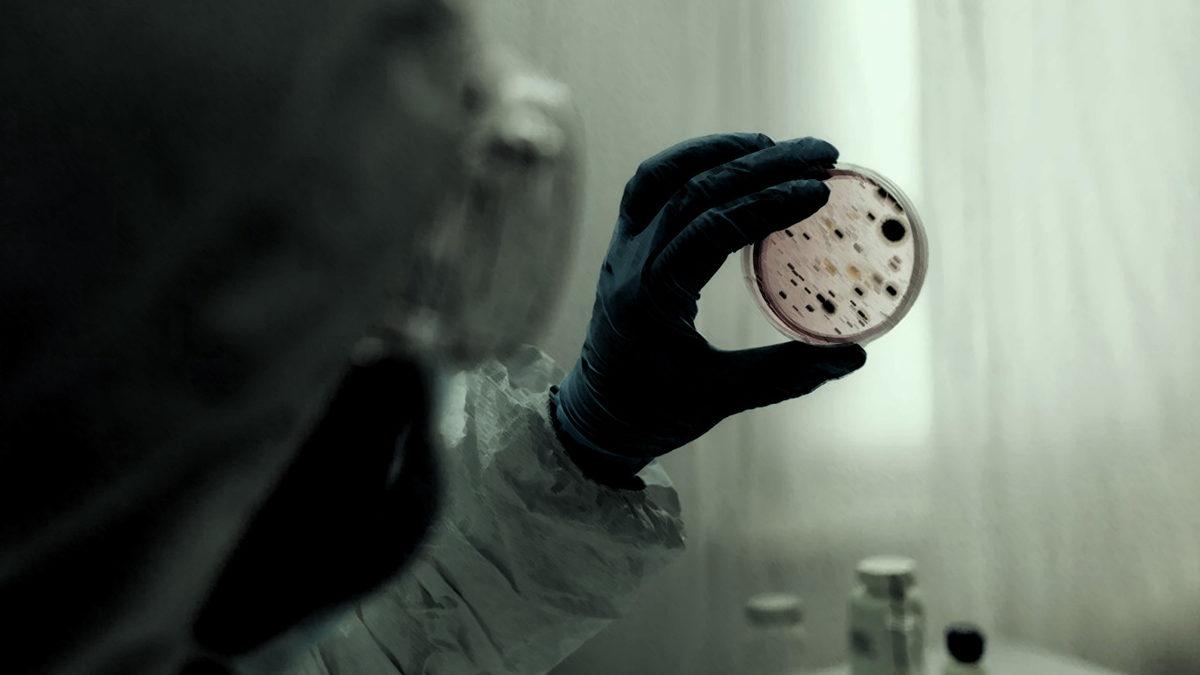
’Strep A’ Bakterisi Yüzünden Çocuğunu Kaybeden Bir Annenin Anlattıkları ve Hastalıkla İlgili Bilmeniz Gerekenler

Covid-19'un ardından gelen salgınlar da halihazırda yorgun olan bünyemizi sarstı. Hatta bunlardan birisi yakın zamanda yaşadığımız ‘geçmeyen grip’ hastalığıydı. Biz böyle adlandırıyoruz çünkü hastalık bir türlü geçmiyor, insanları yaklaşık 2 ay yatak döşek hasta ediyordu. Uzmanlar Covid-19 sonrası pek çok virüs vakasında artış yaşandığını doğruladı. Bugün bahsedeceğimiz virüs de bunlardan biri. Ancak ‘grip’ten çok daha korkunç. Çünkü çocukları bile hayattan koparabiliyor...
Spektrokok’u hiç duymuş muydunuz? Strep A bir bakteri türü, yani bir virüs değil. Biliyorsunuz ki virüsler, canlı organizmalar değildir ve yalnızca enfekte ettikleri hücrelerin içinde büyüyüp çoğalabilirler. Ancak bakteriler kendi kendine büyüyen, çoğalan 'canlı' organizmalardır. Bu sebeple bakteri kaynaklı bir salgının sebep olabilecekleri korkunç olabilir.
İçerikten Görseller
+4
Nitekim bakteri, tüm dünyaya yayılmaya devam ediyor ve maalesef Aras da bu bakteri nedeniyle hayatını kaybetti.

- Aras Sönmez.
İngiltere'de son 3 ayda 30 çocuk söz konusu bakteri nedeniyle hayatını kaybetti. Ancak gün geçtikçe tüm dünyada sayılar artmaya devam ediyor. Geçtiğimiz gün Ekşi Sözlük’te bir anne, ilk kez bir başlık açtığını söyledi ve oğlu Aras’ın yalnızca kısa bir süre mücadele edebildiği hastalığı anlattı. Aras şu anda hayatta değil fakat ailesi insanları bilinçlendirmek için seslerini duyurmaya çalışıyor.
Biz de Aras'ın annesi Derya Sönmez ile iletişime geçtik ve bu içeriği yapmak için kendisinden izin aldık. Diliyoruz ki kendisinin yazdıkları ve anlattıkları insanların bilinçlenmesine yardımcı olabilir.
Derya Sönmez'in anlattıklarını bir 'ders' olarak almalıyız.

Doktorlar, belirtileri menenjit veya faranjite benzetebiliyor.



Hastalık kendisini her zaman aynı şekilde belli etmiyor. Çünkü farklı hastalıklara da sebep olabiliyor.
- Boğazda sebep olduğu enfeksiyon.
Strep A olarak da bilinen bakteri, yaygın olarak boğaz ağrısı, yüksek ateş ve ciltteki kızarıklıklarla etkisini gösteriyor. Bu belirtilere zaman zaman morarma, boğaz yolunda iltihaplanma, halsizlik ve kas ağrısı gibi semptomlar da eklenebiliyor. Strep A’yı bu kadar korkutucu yapan etkenlerden biri de farklı hastalıklara sebep olabiliyor olması.
Bunların başında da kızıl hastalığı, impetigo (ciltte kabarcık ve kızarıklıklara sebep olan bir enfeksiyon) ve selülit gibi cilt hastalıkları geliyor. Nadir olarak ise nekrotizan fasiit (cilt altında ilerleyen derin doku enfeksiyonu) ve toksik şok sendromuna (ölüme kadar gidebilen, deride döküntü, soyulma, ishal gibi belirtileri olan bir hastalık) sebep olabilir.
Belirtileri fark ettiğimizde ne yapmamız gerekiyor?
- Strep A bakteriyel enfeksiyonunun neden olduğu kızarıklıklar. (Her zaman bu kadar belirgin olmayabiliyor. Keza Aras'ta sadece pütür pütür küçük kızarıklıklar bulunuyordu.)
Bakteri 18 yaş altı bireylerde çok daha sık rastlanıyor ve ölümcül sonuçlar doğurabiliyor. Bu sebeple çocuğunuzda veya kendinizde belirtilerden herhangi birisine rastlamanız durumunda bir an önce doktora gitmenizi tavsiye ederiz. Zira bakteri vücuda girdikten sonra çok hızlı bir şekilde yayılıyor ve organların iflas etmesine sebep olabiliyor.
Tedavisi var fakat bakteri size bunun için zaman vermeyebilir.

İlk belirtiler sonrası hastalığın tespitinin ardından bir an önce tedaviye başlanması gerekiyor. Hastalığın bir aşısı yok, yalnızca antibiyotikle tedavi edilebiliyor. Ancak biraz önce de bahsettiğimiz gibi bakteri vücutta çok hızlı ilerlediği için hastalığın erken tespiti oldukça önemli. Geç kalınması durumunda iç organlarda kalıcı hasar, bilinç kaybı ve ölüm gerçekleşebilir.
Hastalığın bulaşıcılık oranı ise çok yüksek.
- Strep A'nın mikroskop altındaki görüntüsü.
Bakteri öksürme, hapşırma ve yakın temas yoluyla bulaşabilir. Bununla birlikte vücudunuzdaki herhangi bir açık yara da bakterinin vücudunuza girmesine sebep olabilir.
20 yılı aşkın süredir virüslerle ilgili araştırmalar yapan Virolog ve Biyoteknoloji Uzmanı Dr. Semih Tareen, Strep A bakterisiyle ilgili şunları söylüyor:
Peki ne oldu da Strep A vakaları artmaya başladı?
İçeriğimizin başında ‘geçmeyen grip’ten bahsetmiştik. Bu yıl çok daha fazla insanın grip olmasının ve daha geç iyileşmesinin sebebi Covid-19 olarak görülüyor. Pek çoğumuz Covid-19'un başladığı günden bu yana kalabalık ortamlara girmiyor, mümkün olduğunca diğer insanlardan izole bir hayat sürüyorduk.
Covid-19'un etkilerinin azalmasının ardından da virüsler için vücudumuz kolay bir hedef haline geldi. Dolayısıyla da yakalandığımız hastalıkları daha ağır yaşıyor ve daha geç atlatıyoruz. Geçtiğimiz günlerde BMJ’de yayınlanan bir araştırma da pek çok hastalıkta vaka sayılarının Covid-19 sonrası artışa geçtiğini gözler önüne seriyor.
Uzmanlara göre vaka sayılarındaki bu artışın sebebi Strep A bakterisinin yeni bir formu da olabilir. Ancak bununla ilgili henüz net bir kanıt yok. İçinde bulunduğumuz şartlar bizi, virüs ve bakterilere karşı çok daha dikkatli olmaya itiyor. Bu sebeple vücudunuzu daha çok dinlemenizi, yaşadığınız 'küçük' gibi görünen rahatsızlıkları hafife almamanızı öneriyoruz.
